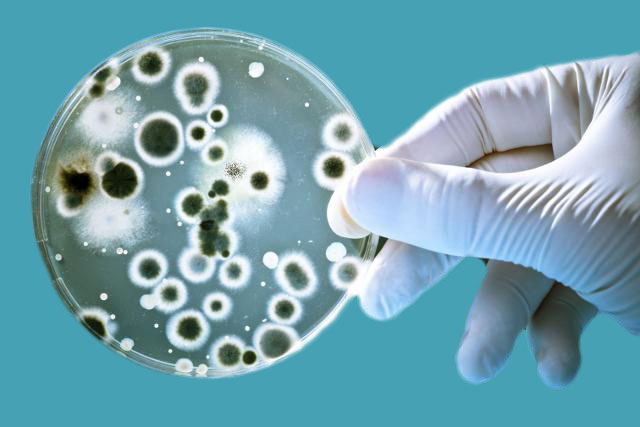

Dr. Harold Cuello Bueno
Patólogo clínico y anatomopatólogo.
Realizamos los exámenes de laboratorio los cuales apoyaran a otras especialidades de la medicina a hacer diagnósticos de las enfermedades.
Contamos con los siguientes exámenes:
· Tamización de cáncer de cuello uterino.
· Toma de citologías Vaginales.
· Recepción de biopsias y especímenes quirúrgicos.
· Recepción de Bacaf o citologías aspirativas de mama y tiroides.